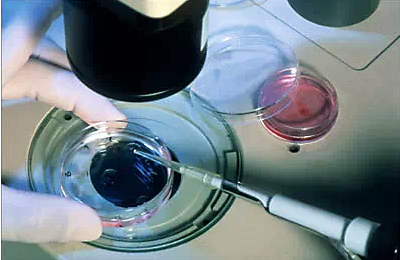

#试管婴儿#
565人参与 92908浏览
-
祝宝宝健康成长,产检一路绿灯
祝宝宝健康成长,产检一路绿灯
51413260 2022-05-30 11:45328 3
-

重组Ⅲ型人源化胶原蛋白――薄型子宫内膜的希望之星
来源:重医大附二院生殖医学中心 备孕路上,不少人面临着无论如何子宫内膜都长不厚的困扰,“内膜不达标取消胚胎移植”成了一些“准妈妈”挥之不去的梦魇。
51390617 2022-05-25 09:16995 3
-
做试管明天取卵,昨天打了夜针,今天一天都好担心卵泡会提前排…
做试管明天取卵,昨天打了夜针,今天一天都好担心卵泡会提前排…
蛋壳壳hhh 2022-04-28 18:09720 3
-

一个成功试管毕业的过来人告诉你,做了试管婴儿我才知道的事
做了试管婴儿我才知道的事最近在调理身体,有空就看一些关于试管的资料,看到一些帖子,发现很多人对试管还是有很多误区的,所以就想出一篇扫盲文,说一下关于三代试管的那些事。一个成功试管毕业的过来人告诉你,试管避雷这4个误区要牢记。
50846474 2022-04-17 07:151479 3
-
试管婴儿技术之“一代、二代、三代”,都有这些区别!
转自重医大附二院生殖医学中心 人类辅助生殖技术近三十年来在我国得到了蓬勃发展,成为治疗不孕不育症的重要方法之一。“试管婴儿”技术发展到今天,“一代、二代、三代”又是什么意思呢?具体详情如何,快来了解一下吧? 一代试管婴儿技术 试管婴儿(专业术语叫体外受精与胚胎移植术)是指取出卵子到体外,在实验室里让卵子与精子结合,待形成胚胎后将胚胎移植到妈妈子宫里,使得胚胎着床发育成胎儿的全过程。最初体外受精是在
50296890 2022-03-23 16:041287 3
-

从做试管被拒到可见明显卵泡,任何时候都可以相信医生!
25岁的周女士,从去年7月开始就不来月经了,中间为了来月经吃过激素,但是一停吃就不来了,想去做试管,但是医院检查她的卵巢萎缩没有卵泡,同时amh只有0.07,不能做试管,后来也尝试过中医调理,但是效果不大,后来去看了医生,医生根据周女士的情况先给她做了3个月的调理方案并且搭配合理的饮食和适当的运动建议,9月份的时候,周女士的检查结果显示卵巢正常并且已经有明显的卵泡了,虽然还需要继续调理,但是有改善
41538457 2021-12-09 10:381301 3
-

试管婴儿5次都失败了,专家看了之后说你这个可以自己怀!
试管婴儿5次都失败了,专家看后说:你这个可以自己怀!刘女士,28岁,结婚多年不孕。当地医院检查后,决定做试管婴儿。结果抑制了5次,都失败了。来北京,挂专家号,找找原因。专家也很纳闷,这么年轻,宫腔也没有问题,按说不应该呀!准备宫腹腔镜探查一下!结果进入腹腔后,发现子宫,卵巢,输卵管都没问题。却发现了大量的子宫内膜异位症病灶!终于找到原因了!就是子宫内膜异位惹得祸!在电凝下,灭活了病灶,手术顺利结束
48831567 2021-11-29 22:003950 3
-
为什么试管婴儿还会宫外孕呢?胚胎不是放到子宫里面的吗?
亲戚好不容易做试管怀孕,结果今天检查出来说是宫外孕,要做手术。为什么试管婴儿还会宫外孕呢?胚胎不是放到子宫里面的吗?胚胎还会到处跑的?
50350470 2021-05-31 14:22546 3
-
关于试管的问题
亲们,染色体一般要两个月才出结果吗?
50688336 2021-03-24 08:50532 3
-

试管婴儿没有你想象中的那么复杂,简单来说5个步骤就完成了
提到试管婴儿,大家第一反应是很复杂很高深,但其实做试管婴儿没有你想象中的那么复杂。试管过程主要分为促排、取卵、胚胎培养、移植、验孕等5个步骤。 这是一位医生分享的试管过程:需要试管助孕的夫妇,做试管婴儿前医生都会要求夫妻进行术前检查,确定女方能否耐受妊娠、有没有并发症、合并症、禁忌症等。如果体检发现某种疾病可能影响受孕或者胎儿健康,会要求先治疗。 1、促排卵:根据每个人的具体情况采用不同的促排方案
42424545 2021-03-23 16:141699 3
-

我国未婚女性不能申请精子库:申请精子库需准备3个证件
4月13日,#清华张小年 人类精子库#话题冲上热搜,有网友开始探讨我国捐精规定。资料显示,捐精指捐精志愿者通过电子精子库或相关生育研究机构,捐献者将精子捐献给相应的生育研究机构,通过供精者与求精方在不发生性关系情况下,使后者达到受孕目的的一种人工辅助生育技术与手段。在我国,未婚女性不可以申请精子库,申请精子库需要准备三个证件:结婚证、身份证和不孕不育证明。
达达飞扬 2023-04-14 08:11443 2
-

医院回应弄错试管婴儿:没必要计较
这问题牵涉可以很广,他们这对夫妇当初胚胎放错了,同一期的所有胚胎植入都可能因为管理而发生失误。如果问题成立,就是一堆孩子和父母对不上号,问题就大了,这就是医院说查不到,追踪不到的最大原因,可能是在掩盖他们的重大失误。建议差不多时间在同一医院做试管的夫妻都去查一下孩子是否是亲生的。事已至此,只有往好的方面想了,从谁的肚子里生出来的就是谁的孩子,既然找不到他血缘父母,又养了这么多年,还是有感情的,别告
51351220 2023-02-20 14:20467 2
-
移植后确定着床,发现新冠阳性了,又该么办?
移植后确定着床,发现新冠阳性了,又该么办?发烧时能吃药吗?这种情况下按照孕妇感染新冠来处理,可以吃药,但是,对药物有严重需求。建议在生殖科或妇科专家指导下治疗新冠感染。
50197839 2022-12-30 20:091713 2
-
AMH只有0.068了,试管还有希望吗?
陈医生,AMH只有0.068了,试管还有希望吗? 陈庆华大夫建议:你好, AMH在临床上被称为抗苗勒氏管激素,正常范围在2-6.8ng/ml之间,在此范围以内数值越高代表卵巢的储备能力越强,说明卵巢的功能比较好的。相反如果数值越低,代表卵巢储备功能越差。AMH数值随着年龄的增长而逐渐降低,女性一般在35岁之后AMH值会开始急剧下降,当AMH低于1.0ng/ml时,表示卵巢的储备功能已经很差了,受孕
31416054 2022-09-30 09:25839 2
-
婆子妈说女儿越来越不像我,该告诉她真相吗?
本女子淑女一枚,平时除了上班就宅在家,带娃自然是婆子妈的事情。我家闺女天生活泼好动,女汉子性格,摸不得的要去摸一下。婆子妈时不的还说你一点都不像你妈妈亲生的。 随着闺女年龄的增长,有一次婆子妈语出惊人:“乖孙女,你怎么长得一点都不像你妈妈呢?”。第一次听说这话我心里咯噔一下,难道婆子妈知道真相了?不可能啊,关于女儿的身世问题不是之前就和我老公说好了的吗?不告诉任何人,永远只能我两个知道。 我不止一
豆角豆丁 2022-09-20 15:111506 2
标签简介
大家都在讨论"试管婴儿"赶紧来看看吧~

